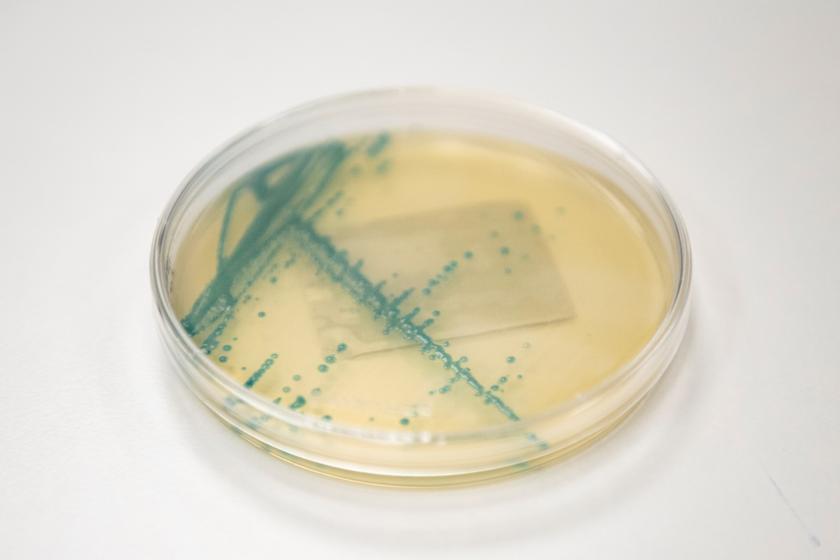
Sikiölle mahdollisesti haitalliset infektiot

Teratologinen tietopalvelu - Odottavan ja imettävän lääkeneuvonta
Asiasanat:Annamme tietoa hedelmällisyyteen, raskauteen ja sikiön kehitykseen haitallisesti vaikuttavista lääkkeistä sekä muista ulkoisista tekijöistä. Meiltä saat neuvontaa myös imetyksen aikaista lääkitystä koskevissa kysymyksissä. Voit ottaa meihin yhteyttä jo raskauden suunnitteluvaiheessa.
Odottaville ja imettäville henkilöille
Kotisivuiltamme löytyy paljon perustietoa lääkkeistä sekä tavallisten raskaudenaikaisten oireiden hoidosta. Jos et löydä vastausta kysymykseesi täältä, voit olla meihin yhteydessä joko puhelimitse tai chatin kautta. Palvelun ollessa suljettuna voit olla yhteydessä omaan neuvolaan tai äitiyspoliklinikkaan.
Emme puutu odottavan tai imettävän hoitoon, raskauden kulkuun tai lapsen hoitoon. Emme määrää lääkkeitä. Jos asiasi koskee työssä tapahtuvaa altistusta tai riskiä, otathan yhteyttä omaan työterveyshuoltoosi.
Teratologisen tietopalvelun chat (Avautuu uuteen ikkunaan. Linkki vie toiselle verkkosivulle.)
Chat-palvelussa vastaamme vain yksinkertaisiin kysymyksiin. Jos haluat kysyä useasta lääkkeestä/muusta aineesta, otathan yhteyttä puhelimitse. Chat-palvelu on avoinna maanantaisin ja torstaisin klo 13–15.

Ammattilaisille
Meihin voivat olla yhteydessä myös terveydenhuollon ammattihenkilöt, apteekit ja viranomaiset sekä tiedotusvälineet. Terveydenhoitohenkilöstö voi tarvittaessa ottaa yhteyttä potilaita koskevissa kysymyksissä myös alta löytyvällä yhteydenottolomakkeella.
Ammattilaisten yhteydenottolomake (Avautuu uuteen ikkunaan. Linkki vie toiselle verkkosivulle.)
Terveydenhuollon ammattilaiset voivat konsultoida Teratologista tietopalvelua tällä lomakkeella. Palvelun käyttö vaatii tunnistautumisen.

Ajankohtaista: Influenssarokote
Vastustuskyky alenee raskauden aikana ja riski sairastua vaikeaan influenssainfektioon ja sen jälkitauteihin, kuten keuhkokuumeeseen, on koholla. Tämän vuoksi influenssarokotetta suositellaan kaikille raskaana oleville raskauden kestosta riippumatta. Inaktiivisten influenssarokotteiden ei ole todettu lisäävän sikiöriskiä, ja rokotteita pidetään turvallisena.
Influenssarokotteen voi turvallisesti ottaa myös imetyksen aikana.
Ajankohtaista: Nuha ja yskä – perushoito tärkeä ja lääkettä vain lyhytaikaisesti
Raskaana ollessa flunssan perushoitoon kuuluvat lepo, lämpimien juomien nauttiminen ja tarvittaessa höyryhengitys, joka irrottaa limaa ja avaa hengitysteitä.
Tukkoisen nenän hoitoon voi tarvittaessa lyhytaikaisesti käyttää ksylometatsoliinia tai oksimetatsoliinia sisältäviä nenäsuihkeita. Nämä lääkkeet supistavat kuitenkin voimakkaasti verisuonia, ja tarkan annosteluohjeen noudattaminen on tärkeää. Sumutteena oleva valmiste on yleensä helpompi annostella kuin tipat.
Yskänlääkkeiden teho on kyseenalainen, eikä yskänlääkkeiden käyttö yleensä ole selkeästi perusteltua. Monet valmisteet sisältävät lukuisia eri vaikuttavia ainesosia, joista valtaosasta ei ole tehty tutkimuksia raskauden aikaisen käytön turvallisuudesta. Yskänärsytyksen lievittämiseen itsehoitolääkkeistä voi tarvittaessa käyttää dekstrometorfaania, ja limaa irrottavista valmisteista esimerkiksi bromheksidiiniä tai guaifenesiiniä.
Imetyksen aikana pätevät samat periaatteet.
Anna meille palautetta
Vauva haaveena
Monet altistukset voivat vaikuttaa hedelmällisyyteen, ja ensimmäisen raskauskolmanneksen viikot ovat herkkiä sikiön epämuodostumien kannalta. Onkin tärkeää huomioida jo raskautta suunniteltaessa, mitkä altistukset voivat olla haitallisia sikiön kehitykselle.

Raskaus ja foolihappo
Sikiön elimistö muodostuu alkuraskauden aikana 12. raskausviikon loppuun mennessä. THL suosittelee kaikille raskautta suunnitteleville naisille monipuolisen ruokavalion lisäksi päivittäistä 0,4 milligramman foolihappovitamiinilisää jo kaksi kuukautta ennen ehkäisyn...

Huomioitavaa raskauden ja imetyksen aikana
Seurantatutkimus lääkkeiden käytöstä raskauden aikana (Avautuu uuteen ikkunaan. Linkki vie toiselle verkkosivulle.)
Haluatko auttaa kartuttamaan tietoa lääkkeiden raskauden aikaisen käytön turvallisuudesta? Voit auttaa keräämään tietoa osallistumalla seurantatutkimukseen.

Naistalo (Avautuu uuteen ikkunaan. Linkki vie toiselle verkkosivulle.)
Naistalosta saat tietoa naistentaudeista, synnytyksistä, hedelmällisyydestä sekä lapsettomuustutkimuksista ja -hoidosta. Terveyskylää ylläpitävät Suomen yliopistosairaalat.

Päivitetty: 09.01.2026